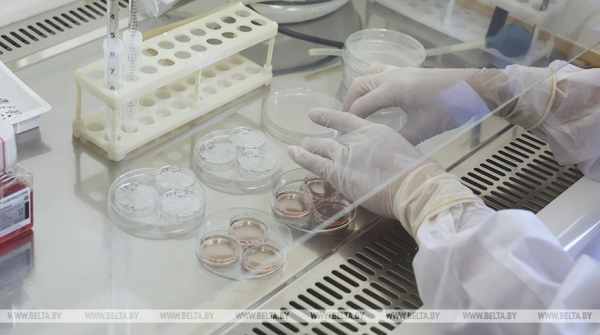
В Конго зафиксирована крупнейшая за 25 лет вспышка холеры

В Конго зафиксирована крупнейшая за 25 лет вспышка холеры
Опубликовано:

В мире 09 декабря 2025, 00:36 В Конго зафиксирована крупнейшая за 25 лет вспышка холеры

Фото из архива 9 декабря, Минск /Корр. БЕЛТА/. В Демократической Республике Конго зафиксировали более 64 тыс. случаев холеры за девять месяцев, при этом болезнь особенно часто поражает детей. Об этом пишет ТАСС.
В 2025 году в ДР Конго зарегистрировали 64 427 случаев холеры, включая 1888 смертей. Среди заболевших значатся 14 818 детей, из которых 340 скончались. Вспышка стала самой крупной за последние 25 лет.
Болезнь охватила 17 из 26 провинций страны. Один из наиболее серьезных очагов находится в столице государства, Киншасе.
Холеру можно предотвратить – для этого требуется увеличить государственные инвестиции в улучшение систем водоснабжения, санитарии и медобслуживания в зонах риска.
Холера передается через воду и пищу, зараженные холерными вибрионами. Поэтому особое внимание следует уделять мерам профилактики для защиты населения, особенно детей, проживающих в районах с уже имеющимися случаями заболевания.
По оценкам ВОЗ, ежегодно из-за нехватки чистой воды, санитарии и гигиены гибнут 1,4 млн человек, а миллиарды не имеют доступа к безопасным туалетам.-0-
Источник: www.belta.by